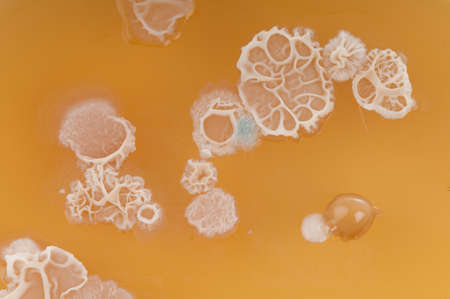
Bacterial colonies mainly Bacillus subtilis  probably  from dirty hands cultured on malt agar in a petrie dish   Macro の写真素材

写真素材 - Bacterial colonies mainly Bacillus subtilis probably from dirty hands cultured on malt agar in a petrie dish Macro
作品情報
Bacterial colonies mainly Bacillus subtilis probably from dirty hands cultured on malt agar in a petrie dish Macro
- ID:14985277
- 作品種別:写真
- 作者名:Brian Maudsley
キーワード
- analysis
- bacillus
- bacteria
- bacteriology
- bacterium
- biotechnology
- colonies
- contaminated
- contamination
- culture
- danger
- dirt
- dirty
- disease
- dish
- disinfect
- fungi
- germs
- growth
- hands
- hazard
- health
- hygiene
- hyphae
- lab
- laboratory
- life
- malt
- media
- medical
- medicine
- microbe
- microbial
- microbiology
- microorganism
- mycelia
- organism
- petri
- plate
- research
- risk
- safety
- sanitation
- science
- scientific
- sickness
- sneeze
- subtilis
- toxic
- agar
類似作品
Backgrounds of ...
Texture of natu...
Backgrounds of ...
Backgrounds of ...
Hands holding a...
Backgrounds of ...
Yeast in petri ...
Staphylococcus ...
Abstract ink te...
Backgrounds of ...
Melioidosis sic...
Backgrounds of ...
iron textures
Colony characte...
Colonies of mic...
Backgrounds of ...
Backgrounds of ...
Backgrounds of ...
Yeast in petri ...
Mixed of bacter...
Colony characte...
Staphylococcus ...
Abstract ink te...
Backgrounds of ...
Bacterial colon...
Backgrounds of ...
Backgrounds of ...
Backgrounds of ...
Bacterial colon...
Backgrounds of ...
Air bubbles ins...
Backgrounds of ...
Black bacterial...
Vibrio cholerae...
Backgrounds of ...
Bacterial cultu...
Two Petri dishe...
Backgrounds of ...
Backgrounds of ...
Mold Beautiful,...
Bacterial colon...
Yeast in dough ...
Yeast in petri ...
Black bacterial...
Characteristics...
Backgrounds of ...
Backgrounds of ...
Micrococcus lut...
Agar plate with...